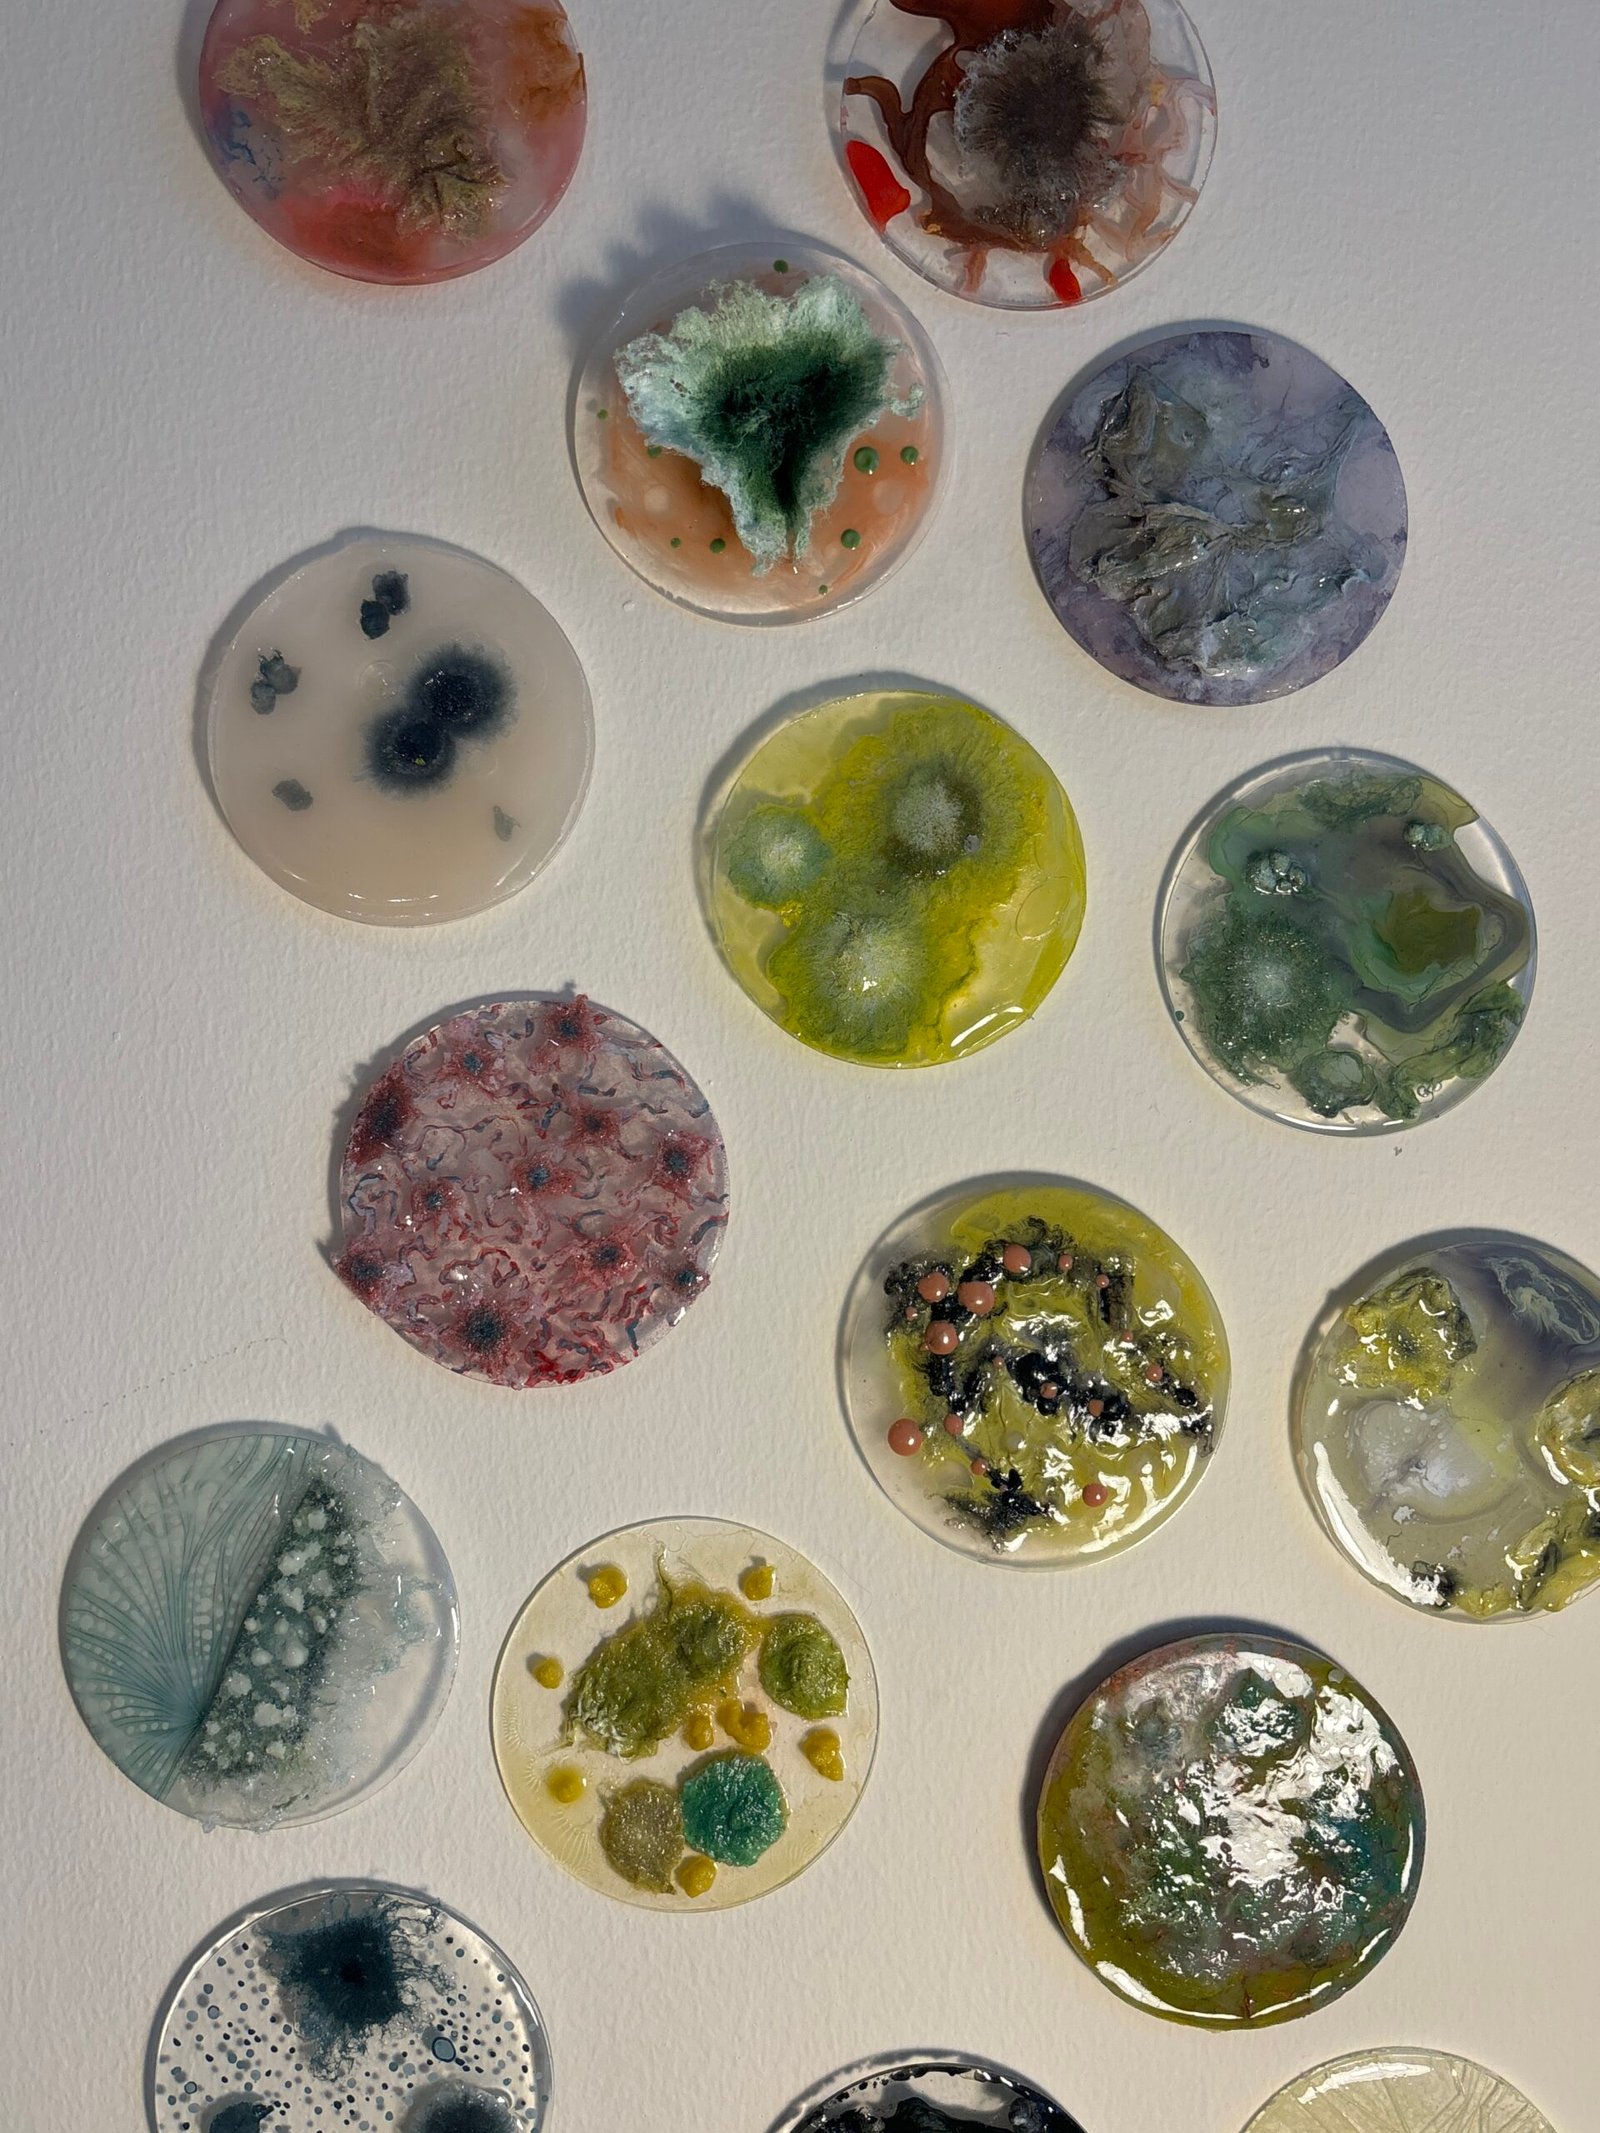
IMG_0677

Mariam Al Mheiri
Mariam Al Mheiri is an artist based in Abu Dhabi. Her practice is deeply inspired by organic creatures, habits, and environments.
Your work is heavily inspired by organic creatures, habits, and environments. How did that inspiration begin?
As we talk with Mariam Al Mheiri, she brings the conversation back to the body.
“My work took an organic direction when I began reflecting on my body-shaming experiences,” she tells us. “I wanted to capture how it feels, like being poisoned, overwhelmed, and slowly fading away.”
We note how research becomes a gateway rather than a method.
“Discovering poisonous mushroom species felt like entering a parallel world,” she says. “That was the aha moment that opened endless artistic possibilities.”
How do inspiration and intuition shape your work?
We notice a clear rhythm between thinking and feeling.
“Inspiration comes through research,” Mariam explains, “especially when I see how closely nature mirrors human emotion.”Intuition, she tells us, arrives instantly.
“It steps in when a texture or organic form connects me to a memory or feeling.”
Looking at your work now, what part of yourself do you see most clearly in it?
“I see the weight of the memories I carried throughout my life,” Mariam says. “Turning those heavy experiences into visible forms reflects both my fragile self and my strength.”
If someone walked into your studio for the first time, what would you want them to leave with?
“I’d want the work to stay with them,” Mariam tells us. “Maybe unsettling, but curious, like it stirred something personal.”
We leave the studio with that feeling in mind, a quiet trace of her work lingering with us, asking to be felt rather than understood.
Stay Connected
Subscribe to receive updates about new workshops, artist features, and upcoming programs.